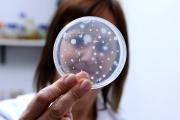
La UNLP trabaja en una solución microscópica para la contaminación de Vaca Muerta

Sociedad
20 de diciembre de 2025 Página 8
El Servicio Meteorológico Nacional (SMN) emitió su pronóstico del tiempo y reveló que se esperan tormentas para este sábado 20 de diciembre en el Área Metropolitana de Buenos Aires (AMBA).Leé también: Así va a estar el clima hoy en tu ciudad: seguí el pronóstico... + más
Alerta amarilla en el AMBA: se adelantan las lluvias y llegan tormentas fuertes esta noche | Infocielo
Un incendio de importante magnitud se activó a las 13.30 de este viernes en la ciudad de Bariloche, específicamente en la zona del cerro Runge, en el kilómetro 1 de la avenida Bustillo. Allí trabajan los Bomberos Voluntarios, que están conteniendo las llamas para evitar que... + más
Bariloche, anfitriona de un evento que reúne a más de 10 mil deportistas de todo el mundo | Diario Río Negro
El instituto que nació para acercar la ciencia y la tecnología a los productores rurales cumplió 60 años en Bariloche | Diario Río Negro
Universidades La UNLP trabaja en una solución microscópica para la contaminación de Vaca Muerta Investigadores de la Universidad Nacional de La Plata desarrollan un inoculante biológico basado en microorganismos autóctonos de Neuquén para degradar hidrocarburos en suelos... + más

A través de una conferencia de prensa, autoridades municipales brindaron detalles de cómo se van a realizar los controles sobre la venta de pirotecnia sonora durante las fiestas de fin de año. General Güemes Becas al mérito: Güemes distinguió a estudiantes... + más
Jugando con pirotecnia, nenes causaron un incendio de pastizales y pusieron en riesgo viviendas del barrio | LMNeuquen
El mapa de la pirotecnia en Río Negro y Neuquén: cómo se regula en el Alto Valle | Diario Río Negro

Con la llegada de Navidad y Año Nuevo, varios departamentos de San Juan recuerdan que la venta y el uso de pirotecnia está prohibida, en el marco de ordenanzas municipales y la normativa provincial. Santa Lucía, Capital, Rawson, Rivadavia y Chimbas fueron los primeros... + más
Jugando con pirotecnia, nenes causaron un incendio de pastizales y pusieron en riesgo viviendas del barrio | LMNeuquen
El mapa de la pirotecnia en Río Negro y Neuquén: cómo se regula en el Alto Valle | Diario Río Negro

La Municipalidad de la Ciudad de San Juan invita a vivir la magia de la Navidad en la Feria Navideña, que se celebrará este sábado 20 de diciembre, con una propuesta cultural, artística y gastronómica pensada para toda la familia. La actividad se desarrollará en el Centro... + más

El Grupo Temático de Formación Ciudadana de RAGA Internacional cerró su agenda 2025 con el conversatorio “Jóvenes y crisis de la democracia: desafíos y oportunidades en tiempos de transformación”, un espacio virtual de reflexión que abordó las nuevas formas de... + más
Una infracción de tránsito que muchos conductores cometen a diario puede convertirse en un verdadero dolor de cabeza para el bolsillo. En distintas ciudades del país, estacionar mal ya no es solo una falta leve: las sanciones económicas se actualizaron y algunas Multas... + más

Pasar la Navidad con una situación económica complicada no es fácil. A las ganas de reunirse con la familia y compartir se les suma una fuerte presión social ligada al consumo, los regalos y las comidas abundantes. Cuando el bolsillo no acompaña, estas fechas pueden... + más

Córdoba registra un aumento sostenido de la temperatura desde hace casi dos décadas debido al avance de la isla de calor urbano, según un estudio realizado por investigadores de la Universidad Nacional de Córdoba. El trabajo, que analiza el período comprendido entre 2003 y... + más
La postura que más perjudica la columna al dormir y qué alternativas sugieren los expertos | Infobae
Cuál es la temperatura ideal para un descanso profundo, según la ciencia | Infobae
“Yo me sigo preguntando, por ejemplo, ¿cómo sería Benicio hoy? Veo un nene de siete años, que es la edad que él tendría, o veo a sus compañeritos porque su hermana, Lola, sigue yendo al mismo colegio y pienso: ¿Cómo sería mi hijo? ¿Seguiría jugando al fútbol, le... + más
Después de una semana muy calurosa en el Área Metropolitana de Buenos Aires (AMBA), el Servicio Meteorológico Nacional (SMN) informó que este sábado 20 de diciembre habrá un leve descenso en las temperaturas, aunque advirtió que volverán las precipitaciones. A su vez,... + más

Víctor Sosa llegó a Rincón en 1974 cuando solamente contaba con cuatro cuadras. Salta Misiones, San Martín y Perón. Comentó que era muy duro vivir al comienzo, mucho viento y sin agua. Pero lo importante era hacer patria, comencé viviendo junto a mis padres y a comienzos... + más

El pasado 2 de diciembre, tras un exigente proceso de selección e incubación de proyectos, el equipo de la Universidad de Congreso San Rafael fue seleccionado entre los mejores del país, compartiendo la instancia final con otros cinco equipos provenientes de distintas... + más

Las ráfagas calientes persistirán en ambas jornadas al igual que la posibilidad de tormentas. La máxima promedio provincial se ubicó en los 35 grados y estuvo acompañada de vientos principalmente la zona Norte y Este. De acuerdo al sitio Meteored el pico se tocó a los 37... + más
“No dormir bien trae consecuencias a corto, mediano y largo plazo”, subrayó Pablo Ferrero, médico especializado en sueño durante su visita a los estudios de LN+. Sobre este punto, el experto advirtió que el mal descanso también trae efectos en el funcionamiento de los... + más

Una nueva subvariante del virus influenza A, conocida como subclado K de la gripe H3N2 encendió todas las alertas sanitarias en distintos puntos del mundo. En los últimos días varios países del cono sur confirmaron su detección, entre ellos Chile y Bolivia. Identificada... + más

En el verano no sólo llega la época del descanso: llega el momento de las salidas y las fiestas: un terreno que los tops y remeras vistosas habían conquistado hace ya unos años. No obstante, ningún reinado dura para siempre, mucho menos en el mundo de la moda en el que cada... + más

Si bien estar todo el día pendiente de la hora parece algo normal, esta acción casi automática tiene un significado psicológico. Para los expertos, este comportamiento frecuente ofrece pistas sobre cómo las personas atraviesan su rutina y gestionan sus emociones. El... + más

Un fuerte sismo se registró en San Juan este sábado y se sintió más intenso en Ullum y varios departamentos de los alrededores. De acuerdo a lo informado por el Instituto Nacional de Prevención Sísmica, el movimiento se registró en la madrugada y fue de una magnitud... + más

Más allá de que el Área Metropolitana de Buenos Aires espera un sábado inestable, el Servicio Meteorológico Nacional (SMN) se encargó de lanzar el pronóstico para todo el país, con una alerta meteorológica, que es naranja para cinco provincias y, por otro lado, es... + más

Con la Navidad a la vuelta de la esquina, el mercado Cofruthos se convierte en el destino ideal para quienes buscan productos frescos y a buen precio para sus preparativos festivos. Desde frutas y verduras hasta carnes y productos para la receta tradicional de la Nochebuena, el... + más

Cuidar un limonero y mantenerlo fuerte, verde y libre de afecciones no siempre requiere productos costosos ni químicos agresivos. Según expertos en jardinería, existe una combinación natural y accesible que puede marcar la diferencia en la salud de estos árboles frutales:... + más

Cada perro tiene una energía y un carácter diferente y, según la astrología, esa vibración puede armonizar —o no— con la personalidad de cada signo. Aunque ningún vínculo se explica solo por los astros, muchas personas sienten que ciertos perros “llegan” en el... + más
Notibol. Desde 2006. Central de Noticias.
Notibol es un agregador informático de noticias y no es responsable del contenido de los enlaces a los sitios externos que generan las noticias.
Acerca de Notibol | Contacto | Política de Privacidad | Descargo de Responsabilidad